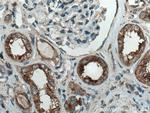
ATP6V0D1 Antibody in Immunohistochemistry (Paraffin) (IHC (P))

Search
Proteintech
ATP6V0D1 Polyclonal Antibody
{{$productOrderCtrl.translations['antibody.pdp.commerceCard.promotion.promotions']}}
{{$productOrderCtrl.translations['antibody.pdp.commerceCard.promotion.viewpromo']}}
{{$productOrderCtrl.translations['antibody.pdp.commerceCard.promotion.promocode']}}: {{promo.promoCode}} {{promo.promoTitle}} {{promo.promoDescription}}. {{$productOrderCtrl.translations['antibody.pdp.commerceCard.promotion.learnmore']}}
产品信息
18274-1-AP
种属反应
已发表种属
宿主/亚型
分类
类型
抗原
偶联物
形式
浓度
规格
纯化类型
保存液
内含物
保存条件
运输条件
产品详细信息
Immunogen sequence: MSFFPELYF NVDNGYLEGL VRGLKAGVLS QADYLNLVQC ETLEDLKLHL QSTDYGNFLA NEASPLTVSV IDDRLKEKMV VEFRHMRNHA YEPLASFLDF ITYSYMIDNV ILLITGTLHQ RSIAELVPKC HPLGSFEQME AVNIAQTPAE LYNAILVDTP LAAFFQDCIS EQDLDEMNIE IIRNTLYKAY LESFYKFCTL LGGTTADAMC PILEFEADRR AFIITINSFG TELSKEDRAK LFPHCGRLYP EGLAQLARAD DYEQVKNVAD YYPEYKLLFE GAGSNPGDKT LEDRFFEHEV KLNKLAFLNQ FHFGVFYAFV KLKEQECRNI VWIAECIAQR HRAKIDNYIP IF (1-351 aa encoded by BC008861)
靶标信息
This gene encodes a component of vacuolar ATPase (V-ATPase), a multisubunit enzyme that mediates acidification of eukaryotic intracellular organelles. V-ATPase dependent organelle acidification is necessary for such intracellular processes as protein sorting, zymogen activation, receptor-mediated endocytosis, and synaptic vesicle proton gradient generation. V-ATPase is composed of a cytosolic V1 domain and a transmembrane V0 domain. The V1 domain consists of three A and three B subunits, two G subunits plus the C, D, E, F, and H subunits. The V1 domain contains the ATP catalytic site. The V0 domain consists of five different subunits: a, c, c', c'', and d. Additional isoforms of many of the V1 and V0 subunit proteins are encoded by multiple genes or alternatively spliced transcript variants. This encoded protein is known as the D subunit and is found ubiquitously.
仅用于科研。不用于诊断过程。未经明确授权不得转售。
生物信息学
蛋白别名: 32 kDa accessory protein; ATPase, H+ transporting, lysosomal (vacuolar proton pump), 42 kDa; ATPase, H+ transporting, lysosomal (vacuolar proton pump), member D; ATPase, H+ transporting, lysosomal 38kDa, V0 subunit D; ATPase, H+ transporting, lysosomal 38kDa, V0 subunit d1; ATPase, H+ transporting, V0 subunit D; FLJ43534; H(+)-transporting two-sector ATPase, subunit D; lysosomal 38kDa; P39; Physophilin; unnamed protein product; V-ATPase 40 KDa accessory protein; V-ATPase AC39 subunit; V-ATPase subunit d 1; V-ATPase, subunit D; V-type proton ATPa; V-type proton ATPase subunit d 1; Vacuolar proton pump subunit d 1
基因别名: Ac39; AI267038; ATP6D; ATP6DV; ATP6V0D1; P39; VATX; VMA6; VPATPD
UniProt ID: (Human) P61421, (Mouse) P51863
Entrez Gene ID: (Human) 9114, (Rat) 291969, (Mouse) 11972